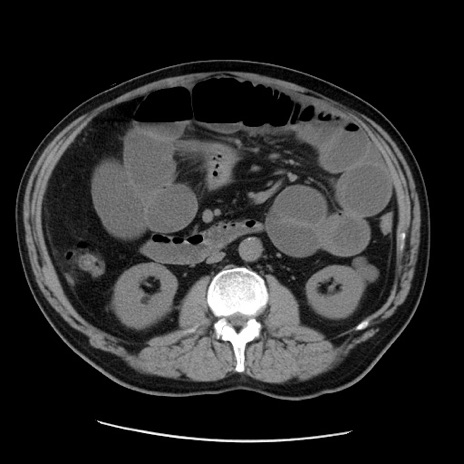
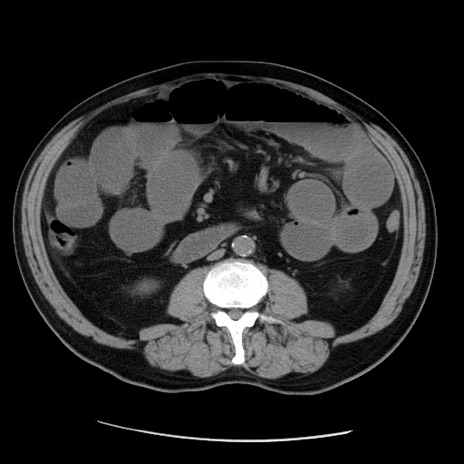
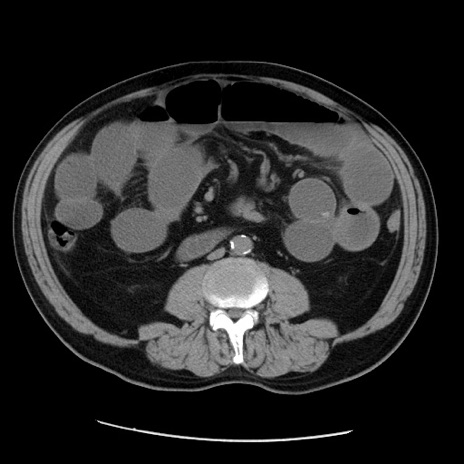

症例20(横断像)
症例
【症例】 60歳代男性
【主訴】 腹部膨満、嘔吐
【現病歴】5日前頃より倦怠感を認め食事量減少し4日前の朝嘔吐、食事摂取困難となった。 3日前近医受診し点滴施行され整腸剤などを処方された。 当日他院を受診し、腹部膨満著明、炎症反応の上昇(CRP10.8、WBC11200)あり、紹介受診となる。
【既往歴】 躁うつ病(抗精神病薬多数内服あり)
【身体所見】 意識JCS1 受け答えがはっきりしないBP 111/57mHg、 P 67bpm、、BT35.2°C、SpO2 97%(RA)、 腹部:膨隆、打診で鼓音あり、全体的に圧痛有り、腸蠕動音(-)、反跳痛ははっきりせず。
【データ】WBC 11400、CRP 14.20